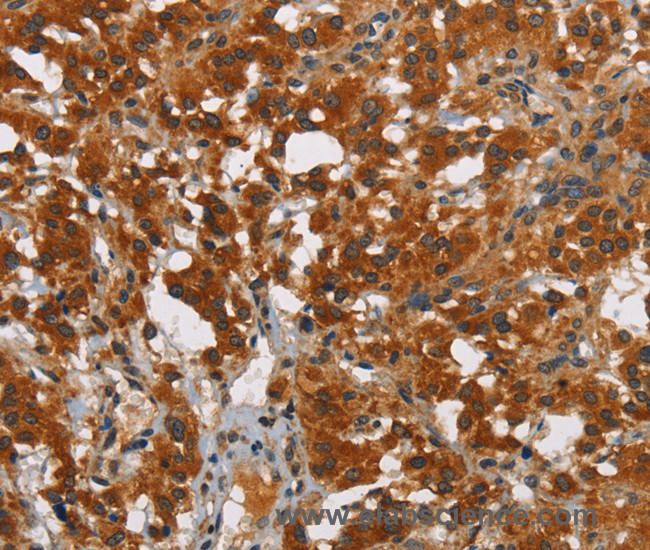
Immunohistochemistry of paraffin-embedded Human thyroid cancer tissue using SMAD9 Polyclonal Antibody at dilution 1:40

Product Description
SMAD9 Polyclonal Antibody | E-AB-13068 | Elabscience
Type: Polyclonal Antibody
Synonyms: MAD homolog 9, Madh6, Mothers against decapentaplegic, Mothers against decapentaplegic homolog 9, Mothers against DPP homolog 9, SMAD 9, SMAD family member 9, SMAD, mothers against DPP homolog 9 (Drosophila), SMAD8A, SMAD8B, Smad9, SMAD9
Application: IHC, ELISA
Reactivity: Human
Host: Rabbit
Isotype: IgG
Reserch Areas: Cancer, Epigenetics and Nuclear Signaling, Metabolism, Signal Transduction, Stem Cells
Background: The protein encoded by this gene is a member of the SMAD family, which transduces signals from TGF-beta family members. The encoded protein is activated by bone morphogenetic proteins and interacts with SMAD4. Two transcript variants encoding different isoforms have been found for this gene.
Concentration: 0.5 mg/mL
Storage: Store at -20°C. Avoid freeze / thaw cycles.
Immunogen: Synthetic peptide of human SMAD9
Buffer: PBS with 0.05% sodium azide and 50% glycerol, PH7.4
Purification Method: Affinity purification
Dilution: IHC 1:50-1:200
Clone: N/A
Conjugation: Unconjugated
Molecular Weight(Calculated): N/A
Molecular Weight(Observed): N/A
 Euro
Euro
 USD
USD
 British Pound
British Pound
 NULL
NULL